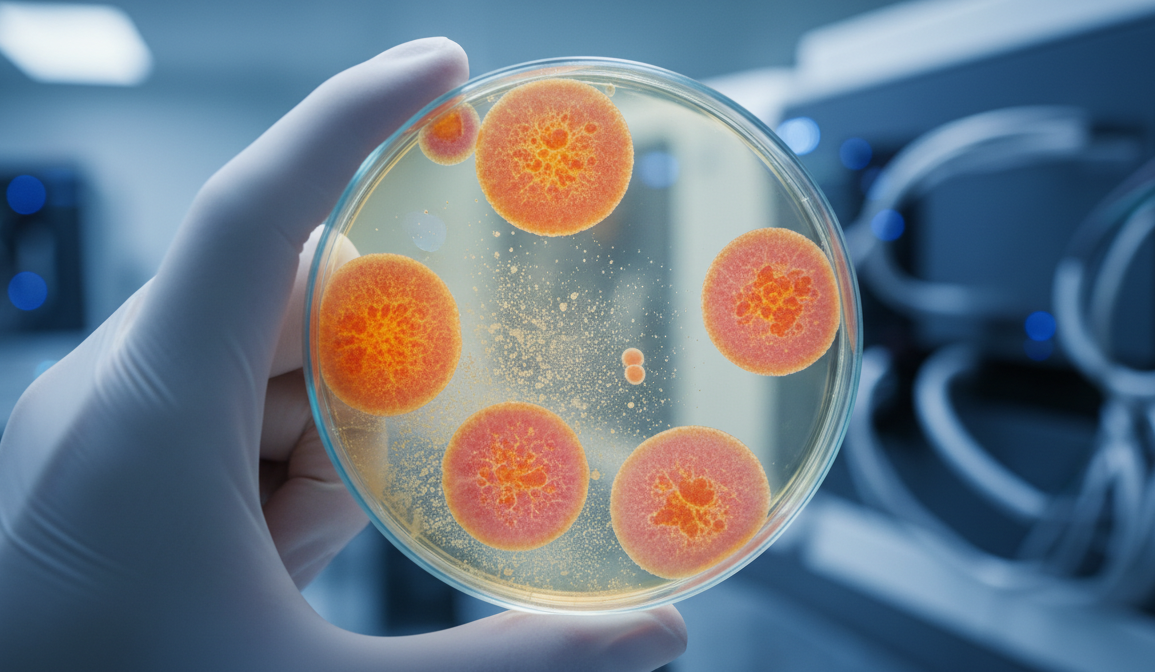

Бактерия возрастом 5000 лет оказалась устойчива к антибиотикам: как устроен иммунитет микроорганизмов, запертых во льдах
В глубине Карпатских гор, на территории Румынии, скрывается пещера Скаришоара. Это гигантский природный холодильник, хранящий внутри себя второй по величине подземный ледник в Европе. Ледяной блок объемом более 100 000 кубических метров формировался тысячелетиями, слой за слоем запечатывая атмосферу, пыльцу и микроорганизмы прошлых эпох. Именно здесь группа биологов обнаружила бактерию, несущую в своем геноме механизмы защиты от большинства современных антибиотиков.
Микроорганизм Psychrobacter sp. SC65A.3 был извлечен из льда возрастом около 5000 лет. Это время соответствует раннему бронзовому веку, периоду строительства первых пирамид в Египте. Бактерия находилась в состоянии анабиоза задолго до открытия пенициллина и начала эры массового применения лекарств. Однако лабораторный анализ показал странный результат: этот древний организм обладает генетически встроенной защитой от большинства современных антибиотиков.
Это открытие заставляет пересмотреть наши взгляды на эволюцию микромира. Оно доказывает, что механизмы лекарственной устойчивости — это не побочный эффект человеческой медицины, а фундаментальный инструмент выживания, отточенный природой за миллионы лет.
Генетическая память о древних войнах
Современное общество привыкло считать проблему супербактерий (микробов, устойчивых к лекарствам) исключительно рукотворной. Мы полагаем, что бесконтрольный прием таблеток и использование антибиотиков в животноводстве спровоцировали мутации, сделавшие инфекции неуязвимыми. Исследование из Скаришоара показывает, что это не совсем так.
Геномное секвенирование штамма SC65A.3 выявило сложную систему защиты. У бактерии, которая никогда не контактировала с современной фармакологией, обнаружены гены, обеспечивающие устойчивость к бета-лактамам (пенициллин, цефалоспорин), тетрациклину, фторхинолонам и аминогликозидам. Это основные классы препаратов, используемые в клиниках сегодня.
Откуда у древнего организма такие способности? Ответ кроется в экологии почвы и воды. Антибиотики — это изначально природные соединения. Грибы и бактерии вырабатывают их, чтобы уничтожать конкурентов в борьбе за пищевые ресурсы. В ответ их соседи вынуждены эволюционировать, вырабатывая ферменты, разрушающие токсины, или насосы, выкачивающие их из клетки.

Механика защиты: как работает древний резистом
Ученые детально изучили резистом — совокупность всех генов устойчивости в ДНК найденной бактерии. Анализ показал наличие более 100 генетических детерминант, отвечающих за выживание в агрессивной среде.
Особый интерес вызывает механизм инактивации антибиотиков. Бактерия несет гены, кодирующие бета-лактамазы класса AmpC. Эти ферменты работают как молекулярные ножницы: они химически разрезают кольцевую структуру молекулы антибиотика (например, пенициллина), делая его бесполезным еще до того, как он успеет навредить клетке.
Кроме того, у SC65A.3 обнаружены гены мультилекарственных эффлюксных насосов. Это сложные белковые комплексы, встроенные в клеточную мембрану. Они действуют как дренажная система: если токсичное вещество попадает внутрь бактерии, насос перехватывает его и выбрасывает наружу. Эффективность этих насосов настолько высока, что они обеспечивают защиту сразу от целого спектра веществ, включая тяжелые металлы (ртуть, кадмий, свинец), что также подтвердилось в ходе тестов.
Не только щит, но и меч
Исследователи обнаружили, что бактерия сама является источником мощных антимикробных соединений. Это логично с точки зрения эволюции: в условиях дефицита питания в холодной среде мало просто защититься от соседа — нужно устранить конкурента.
В лабораторных условиях экстракты SC65A.3 продемонстрировали способность уничтожать современные патогены из группы ESKAPE. Эта аббревиатура объединяет шесть самых опасных внутрибольничных инфекций, обладающих высокой устойчивостью к лечению (включая Staphylococcus aureus, Klebsiella pneumoniae, Pseudomonas aeruginosa). Древняя бактерия успешно подавляла рост даже метициллин-резистентного золотистого стафилококка (MRSA) — одного из главных врагов современной хирургии.
Генетический анализ подтвердил наличие кластеров биосинтеза, отвечающих за производство бактериоцинов и других антимикробных пептидов. Это открывает перед фармакологами новые перспективы. Ледники и пещеры, подобные Скаришоара, могут стать источником принципиально новых молекул для создания лекарств следующего поколения. Вещества, которые бактерии использовали для борьбы друг с другом тысячи лет назад, могут оказаться эффективными против современных инфекций, которые уже привыкли к стандартным аптечным антибиотикам.
Жизнь на пределе: адаптация к вечному холоду
Способность противостоять химическим атакам — не единственный талант штамма SC65A.3. Его выживание в ледяном плену на протяжении 5000 лет требовало полной перестройки метаболизма. Этот организм классифицируется как психорофил (любитель холода) и галофил (любитель соли), способный расти при низких температурах и выдерживать соленость, в разы превышающую морскую.
Главная проблема жизни на холоде — потеря гибкости. При низких температурах клеточные мембраны затвердевают, как масло в холодильнике, блокируя транспорт веществ, а белки сворачиваются неправильно, теряя свои функции. SC65A.3 решил эту проблему на молекулярном уровне.
В его геноме обнаружен расширенный набор генов, отвечающих за реакцию на холодовой шок. Бактерия синтезирует специальные белки-шапероны. Их задача — работать наладчиками: они физически поддерживают правильную трехмерную структуру ферментов, не давая им слипаться или разрушаться на холоде. Кроме того, организм умеет изменять химический состав своей мембраны, насыщая ее жирными кислотами, которые остаются жидкими даже при температурах, близких к замерзанию.
Ферменты, выделенные из таких бактерий, сохраняют активность при низких температурах. В промышленности это позволяет проводить химические реакции без затрат энергии на нагрев. Например, так называемые холодные ферменты уже используются в производстве моющих средств для стирки в холодной воде, в пищевой промышленности и при переработке отходов.

Климатические риски и «генетическое загрязнение»
Открытие в пещере Скаришоара имеет и тревожную сторону. Оно наглядно демонстрирует, что вечная мерзлота и ледники являются гигантским резервуаром спящих бактерий и вирусов. Глобальное потепление ведет к таянию этих природных хранилищ, что неизбежно приведет к высвобождению древней микрофлоры в современные экосистемы.
Опасность заключается не столько в том, что древние бактерии вызовут эпидемии (большинство из них безопасны для человека), сколько в механизме горизонтального переноса генов. Бактерии способны передавать участки своей ДНК соседям, даже если те принадлежат к другому виду.
Существует риск, что гены устойчивости из размороженных бактерий будут переданы современным патогенам. Это может обогатить арсенал болезнетворных микробов новыми, забытыми способами защиты, усложнив и без того непростую ситуацию в здравоохранении.
Заключение: переосмысление стратегии
Исследование Psychrobacter SC65A.3 подтверждает, что резистентность к антибиотикам — это естественное, природное явление, существовавшее задолго до появления человека. Мы не создали эту проблему с нуля, мы лишь ускорили эволюционные процессы своим вмешательством.
Это знание меняет подход к поиску новых лекарств. Вместо того чтобы пытаться синтезировать искусственные молекулы в лабораториях, наука все чаще обращается к природным библиотекам. Экстремальные среды обитания — от глубоководных впадин до ледяных пещер — скрывают в себе биологические решения, которые эволюция тестировала тысячелетиями.
Источник: Frontiers in Microbiology











0 комментариев
Добавить комментарий